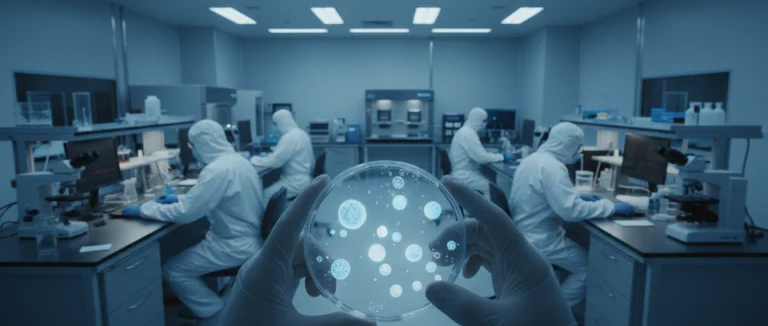

паллиативный уход
пальмито
панкреатит
Паркинсона
пенис
первичная профилактика
Перу
Перфорация
печенью
Питание
пищеварительной
пищевые добавки
ПКС
плечевой сустав
плотность костей
плотные кости
плюрипотентные гемопоэтические стволовые клетки
плюрипотентные клетки
плюрипотентные стволовые клетки
побочные эффекты
повреждение мышцы ноги
повреждения мышц
повреждённые суставы
повторные УИ
повышение либидо
повышенная костная масса
повышенное мочеиспускание
подготовка к DEXA
поддержка мочевого пузыря
поддержка при раке
поджелудочной железы
подкаст доктор Майк
подтекание мочи
позвонки C3 C4 шейный отдел позвоночника
позвоночник
Позвоночник
показатель Глисона 7
полезен ли лёд при артрите
полезно ли тепло при артрите
полная замена сустава
полный медицинский осмотр
получение эрекции
помощь при раке
поставлен диагноз рак
постоянное желание мочиться
почему я так часто мочусь
почечные камни
поясничная дискэктомия
поясничный отдел
преимущества терапии
препараты для контроля мочевого пузыря
препараты для эрекции
препараты от импотенции
препараты от ЭД
препараты при ЭД
признаки ИМП
признаки эректильной дисфункции
причины болей в суставах
причины боли в костях
проблемы с эрекцией
проблемы суставов
продукты
продукты для здоровья суставов
продукты для либидо
продукты для простаты
продукты для роста органа
продукты для эрекции
продукты повышающие либидо
продукты при импотенции
продукты при УТИ
продукты-афродизиаки
прорыв в лечении рака
простата
Простата
простатическая уретра
Простатэктомия
Простатa
протекание мочи
протекающий мочевой пузырь
Противовирусные препараты
противовоспалительная диета
противоречия
Протрузия
Протрузия диска
профилактика
профилактика рака простаты
профилактическая помощь
профилактические услуги
профилактический визит
профилактический осмотр
профилактический скрининг
профилактический уход
профилактическое здоровье
процедура стволовых клеток
процедуры
ПЭТ-сканирование